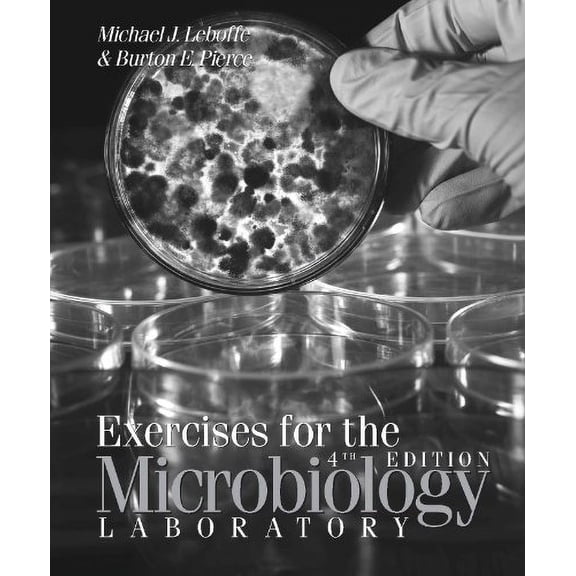
Exercises for the Microbiology Laboratory

Microbiologique(15)
Uses item details. Price when purchased online
Ophtalmologie Microbiologique (Paperback) $28.21

$2821
current price $28.21Ophtalmologie Microbiologique (Paperback)
Biotechnologie microbiologique dans le microneedling esthtique, (Paperback) $43.00

$4300
current price $43.00Biotechnologie microbiologique dans le microneedling esthtique, (Paperback)
Save with
Profil microbiologique des infections hospitalires dans les units de soins intensifs, (Paperback) $43.00

$4300
current price $43.00Profil microbiologique des infections hospitalires dans les units de soins intensifs, (Paperback)
Save with
Analyse microbiologique de l'eau et des eaux uses, (Paperback) $42.00

$4200
current price $42.00Analyse microbiologique de l'eau et des eaux uses, (Paperback)
Save with
Technique Microbiologique Et Srothrapique : Guide Pour Les Travoux Du Laboratoire (Paperback) $30.10

$3010
current price $30.10Technique Microbiologique Et Srothrapique : Guide Pour Les Travoux Du Laboratoire (Paperback)
Contrle de la qualit microbiologique et sanitaire du lait de vache (Paperback) $65.77

$6577
current price $65.77Contrle de la qualit microbiologique et sanitaire du lait de vache (Paperback)
Save with
Utilisation de la nisine et de conservateurs pour contrler la croissance microbiologique, (Paperback) $41.00

$4100
current price $41.00Utilisation de la nisine et de conservateurs pour contrler la croissance microbiologique, (Paperback)
Save with
Indicateurs microbiologiques et chimiques de la qualit des sols et corrlations, (Paperback) $51.00

$5100
current price $51.00Indicateurs microbiologiques et chimiques de la qualit des sols et corrlations, (Paperback)
Save with
Omn.Univ.Europ.: Qualit Microbiologique Du Poisson Fum En Cte d'Ivoire (Paperback) $51.00

$5100
current price $51.00Omn.Univ.Europ.: Qualit Microbiologique Du Poisson Fum En Cte d'Ivoire (Paperback)
Save with
Qualit microbiologique de l'eau consomme dans l'habitat informel, (Paperback) $50.00

$5000
current price $50.00Qualit microbiologique de l'eau consomme dans l'habitat informel, (Paperback)
Save with
Scurit microbiologique des aliments vendus dans les rues de la ville de Jaipur, (Paperback) $46.00

$4600
current price $46.00Scurit microbiologique des aliments vendus dans les rues de la ville de Jaipur, (Paperback)
Save with
Espces mdicinales: concepts et qualit microbiologique, (Paperback) $48.00

$4800
current price $48.00Espces mdicinales: concepts et qualit microbiologique, (Paperback)
Save with
Caractrisation chimico-microbiologique de VITAFERT, (Paperback) $51.00

$5100
current price $51.00Caractrisation chimico-microbiologique de VITAFERT, (Paperback)
Save with
tude Sur l'Importance Hyginique de la Valeur Hydrotimtrique Des Eaux Potables : Juge Au Point de Vue Microbiologique (Paperback) $11.95

$1195
current price $11.95tude Sur l'Importance Hyginique de la Valeur Hydrotimtrique Des Eaux Potables : Juge Au Point de Vue Microbiologique (Paperback)
Save with
tude Sur l'Importance Hyginique de la Valeur Hydrotimtrique Des Eaux Potables: Juge Au Point de Vue Microbiologique (Paperback) $11.95

$1195
current price $11.95tude Sur l'Importance Hyginique de la Valeur Hydrotimtrique Des Eaux Potables: Juge Au Point de Vue Microbiologique (Paperback)
Save with
Other options to consider(30)
Microbiology : a QuickStudy Laminated 6-Page Reference Guide (Other) $6.48

$648
current price $6.48Microbiology : a QuickStudy Laminated 6-Page Reference Guide (Other)
Save with
Textbook of Microbiology for Diploma in General Nursing & Midwifery Students - Kumar, Surinder $29.02

$2902
current price $29.02Textbook of Microbiology for Diploma in General Nursing & Midwifery Students - Kumar, Surinder
Trait D'analyse Chimique Micrographique Et Microbiologique Des Eaux Potables (Paperback) $25.72

$2572
current price $25.72Trait D'analyse Chimique Micrographique Et Microbiologique Des Eaux Potables (Paperback)
Introduction to Microbiology Laboratory Exercises for Allied Health Students

Introduction to Microbiology Laboratory Exercises for Allied Health Students
Save with
Exercises for the Microbiology Laboratory $29.99
$2999
current price $29.99Exercises for the Microbiology Laboratory
Analyses Microbiologiques Du Pouvoir Dsinfectant Des Systmes de MM. Hermite Et Howatson, Rapport: Commission de l'Exposition Internationale d'Hygine de Boulogne-Sur-Mer (Paperback) $11.95

$1195
current price $11.95Analyses Microbiologiques Du Pouvoir Dsinfectant Des Systmes de MM. Hermite Et Howatson, Rapport: Commission de l'Exposition Internationale d'Hygine de Boulogne-Sur-Mer (Paperback)
Save with
Microbiology (Other) $14.28

$1428
current price $14.28Microbiology (Other)
Laboratory Techniques In Basic and Applied Microbiology (Paperback) $51.83

$5183
current price $51.83Laboratory Techniques In Basic and Applied Microbiology (Paperback)
Mthodes de terrain pour l'analyse microbiologique de la qualit de l'eau dans les situations d'urgence, (Paperback) $39.00

$3900
current price $39.00Mthodes de terrain pour l'analyse microbiologique de la qualit de l'eau dans les situations d'urgence, (Paperback)
Save with
Loose Leaf for Microbiology Fundamentals: A Clinical Approach, 2024 Release, 9781265472238, Paperback, 99 $126.14

$12614
current price $126.14Loose Leaf for Microbiology Fundamentals: A Clinical Approach, 2024 Release, 9781265472238, Paperback, 99
Pre-Owned Microbiology: Laboratory Manual for Allied Health and General Microbiology (Unknown) 0840396228 9780840396228 $16.08

$1608
current price $16.08Pre-Owned Microbiology: Laboratory Manual for Allied Health and General Microbiology (Unknown) 0840396228 9780840396228
Les Analyses Microbiologiques des Aliments Adoptes par la Lgislation (Paperback) $43.09

$4309
current price $43.09Les Analyses Microbiologiques des Aliments Adoptes par la Lgislation (Paperback)
Save with
Microbiology : Applications to Patient Care $223.40

$22340
current price $223.40Microbiology : Applications to Patient Care
Practical Bacteriology, Microbiology And Serum Therapy (medical And Veterinary): A Text Book For Laboratory Use (Paperback) $38.95

$3895
current price $38.95Practical Bacteriology, Microbiology And Serum Therapy (medical And Veterinary): A Text Book For Laboratory Use (Paperback)
Save with
Le lait, tudes chimiques et microbiologiques (Paperback) $26.95

$2695
current price $26.95Le lait, tudes chimiques et microbiologiques (Paperback)
Save with
ASM Books: A Guide to Specimen Management in Clinical Microbiology (Paperback)

ASM Books: A Guide to Specimen Management in Clinical Microbiology (Paperback)
Laboratory Applications in Microbiology: A Case Study Approach, (Spiral-Bound) $168.51

$16851
current price $168.51Laboratory Applications in Microbiology: A Case Study Approach, (Spiral-Bound)
Sciences: Le Lait: tudes Chimiques Et Microbiologiques (Paperback) $24.95

$2495
current price $24.95Sciences: Le Lait: tudes Chimiques Et Microbiologiques (Paperback)
Save with
ASM Books 101 Topics for Clinical Microbiology Laboratory Leaders: Accreditation, Verification, Quality Systems, and More, (Hardcover) $77.53

$7753
current price $77.53ASM Books 101 Topics for Clinical Microbiology Laboratory Leaders: Accreditation, Verification, Quality Systems, and More, (Hardcover)
Microbiology: A Laboratory Manual, (Loose Leaf) $183.40

$18340
current price $183.40Microbiology: A Laboratory Manual, (Loose Leaf)
-NA- $27.14

$2714
current price $27.14-NA-
Clinical Microbiology for Diagnostic Laboratory Scientists (Paperback) $140.52

$14052
current price $140.52Clinical Microbiology for Diagnostic Laboratory Scientists (Paperback)
Laboratory Procedures in Clinical Microbiology, (Paperback) $159.04

$15904
current price $159.04Laboratory Procedures in Clinical Microbiology, (Paperback)
Save with
HowExpert Guide to Microbiology: 101 Tips to Learn about the History, Applications, Research, Universities, and Careers , (Paperback) $19.99

$1999
current price $19.99HowExpert Guide to Microbiology: 101 Tips to Learn about the History, Applications, Research, Universities, and Careers , (Paperback)
Save with
Handbook for Microbiology Practice in Oral and Maxillofacial Diagnosis : A Study Guide to Laboratory Techniques in Oral Microbiology $38.89

$3889
current price $38.89Handbook for Microbiology Practice in Oral and Maxillofacial Diagnosis : A Study Guide to Laboratory Techniques in Oral Microbiology
Save with
Related Products
Pre-Owned Hypothyroidism Diet [Second Edition]: Recipes for Hypothyroidism and Losing Weight Fast (Paperback) 1630229334 9781630229337
Pre-Owned Hypothyroidism Diet [Second Edition]: Recipes for Hypothyroidism and Losing Weight Fast (Paperback) 1630229334 9781630229337$8.46current price $8.46Toxemia Explained : The True Interpretation of the Cause of Disease
Toxemia Explained : The True Interpretation of the Cause of Disease$23.48current price $23.48Pre-Owned Introduction to Biofuels (Hardcover) 1439812071 9781439812075
Pre-Owned Introduction to Biofuels (Hardcover) 1439812071 9781439812075$34.99current price $34.99Pre-Owned Introduction to Biofuels (Paperback) 1138116270 9781138116276
Pre-Owned Introduction to Biofuels (Paperback) 1138116270 9781138116276$89.44current price $89.44Pre-Owned Essentials of General, Organic, and Biochemistry (Hardcover) 0030056489 9780030056482
Pre-Owned Essentials of General, Organic, and Biochemistry (Hardcover) 0030056489 9780030056482$11.89current price $11.89